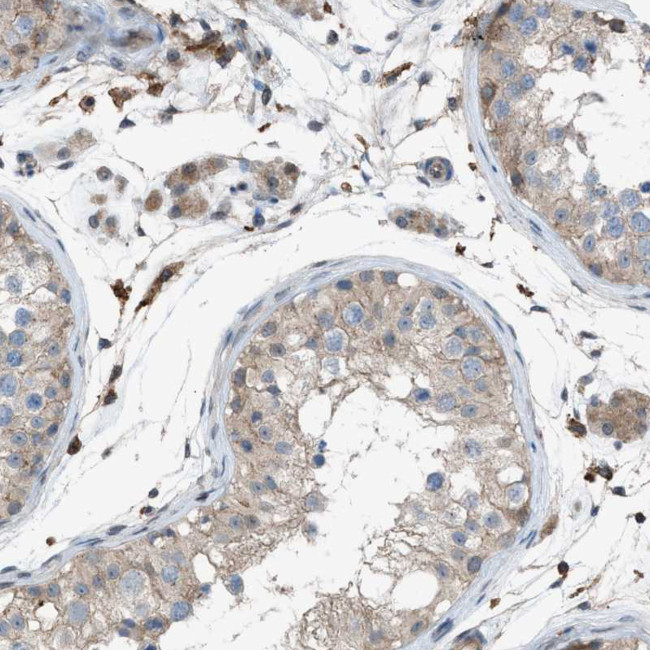
DYRK1A Antibody in Immunohistochemistry (Paraffin) (IHC (P))

Search
产品信息
PA5-110799
种属反应
宿主/亚型
分类
类型
抗原
偶联物
形式
浓度
规格
纯化类型
保存液
内含物
保存条件
运输条件
RRID
产品详细信息
Immunogen sequence: VRQQFPAPLG WSGTEAPTQV TVETHPVQET TFHVAPQQNA LHHHHGNSSH HHHHHHHHHH HHGQQALGNR TRPRVYNSPT NSSSTQDSME VGHSHHSMTS LSSSTTSSST SSSSTG
Highest antigen sequence indentity to the following orthologs: Mouse - 100%, Rat - 100%.
靶标信息
DYRK1A is a dual specificity kinase involved in cell proliferation. The gene for DYRK1A is located in the Down syndrome critical region of chromosome 21, and has been implicated in the pathogenesis of this disease. DYRK1A catalyzes the transition of 3-phosphoglycerate into 3-phosphohydroxypyruvate, which is the first and rate-limiting step in the phosphorylated pathway of serine biosynthesis, using NAD+/NADH as a cofactor.
仅用于科研。不用于诊断过程。未经明确授权不得转售。
篇参考文献 (0)
生物信息学
蛋白别名: dual specificity tyrosine-(Y)-phosphorylation regulated kinase 1A; Dual specificity tyrosine-phosphorylation-regulated kinase 1A; Dual specificity YAK1-related kinase; HP86; mnb protein kinase homolog hp86; MNB/DYRK protein kinase; MNBH; OTTHUMP00000109090; Protein kinase minibrain homolog; serine/threonine kinase MNB; serine/threonine-specific protein kinase; unnamed protein product
基因别名: DYRK; DYRK1; DYRK1A; HP86; MNB; MNBH; MRD7
UniProt ID: (Human) Q13627
Entrez Gene ID: (Human) 1859